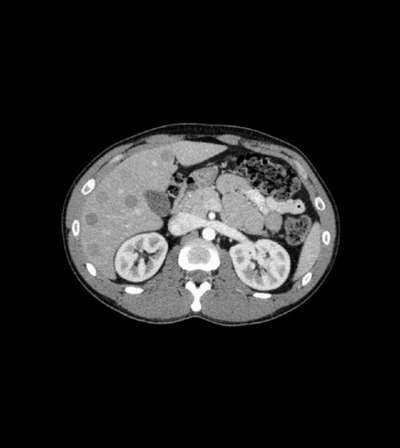
Fantoma de Abdómen

A PhantomX é uma empresa alemã dedicada ao desenvolvimento e fabrico dos fantomas mais realistas para imagiologia médica. Com uma base sólida de mais de uma década de investigação e engenharia, a PhantomX combina conhecimento clínico, perícia científica e excelência tecnológica para criar soluções inovadoras que asseguram a validação de tecnologias de imagiologia médica, segurança diagnóstica e implementação eficaz de inteligência artificial antes da aplicação em pacientes.
Com origem em projetos de investigação no Hospital Universitário Charité, em Berlim, a PhantomX mantém parcerias estreitas com instituições médicas, entidades de investigação, estabelecimentos de ensino e organismos reguladores a nível global.